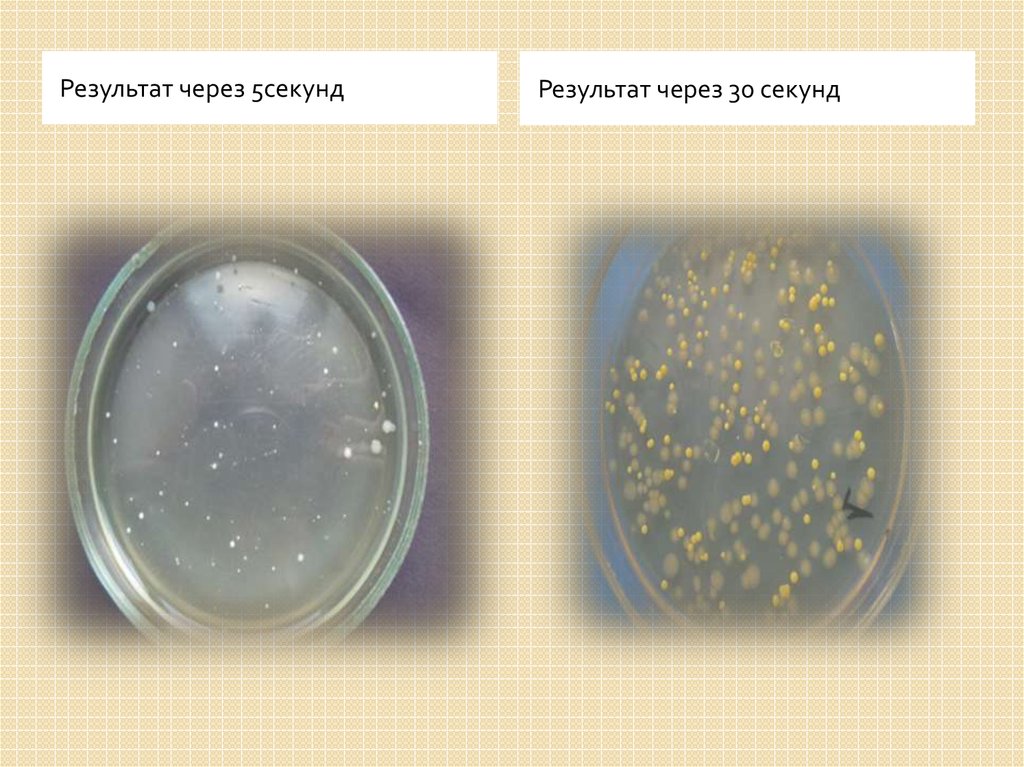

Похожие презентации:
Расчет скорости перемещения бактерий с одной поверхности на другую
1. Команда по следам Боткина Задача №6 Что упало – то пропало
Петракова Виталия2. Задача: Существует мнение, что если сто – то съедобное уронить на пол и поднять меньше чем через 30 секунд то его всё ещё можно
есть.Рассчитайте
скорость перемещения бактерий с одной
поверхности на другую. Поставьте эксперимент.
3. Условия эксперимента: 1.Гладкая поверхность соприкосновения (стол, пол) 2. Два предмета из одного материала – мы брали
предметные стёкла.3. Оба испытуемых предмета должны быть
стерильны!
4. Прожжённые предметные стёкла помещаются на поверхность одновременно на близком расстоянии.(Что –бы обеспечить одинаковые
условия эксперимента).5. Первое стекло – снимается с поверхности через 5 секунд. Второе стекло – через 30 секунд. Затем методом смывов определяем общее
микробное число поверхности испытуемых стёкол.6. Общее микробное число (ОМЧ) – это количественный показатель, отражающий общее содержание мезофильных аэробных и факультативно
Общее микробное число (ОМЧ) – этоколичественный показатель, отражающий общее
содержание мезофильных аэробных и
факультативно анаэробных микроорганизмов в 1
мл исследуемой воды.
7.
Результат через 5секундРезультат через 30 секунд
8. Эксперимент повторяется до 30 раз(Для получения статистических достоверных результатов).При желании можно использовать не два а
большее количество стёколи снимать их с разным промежутком времени через
5 – 10 – 15 – 20 – 25 – 30 секунд.

Медицина
Медицина








